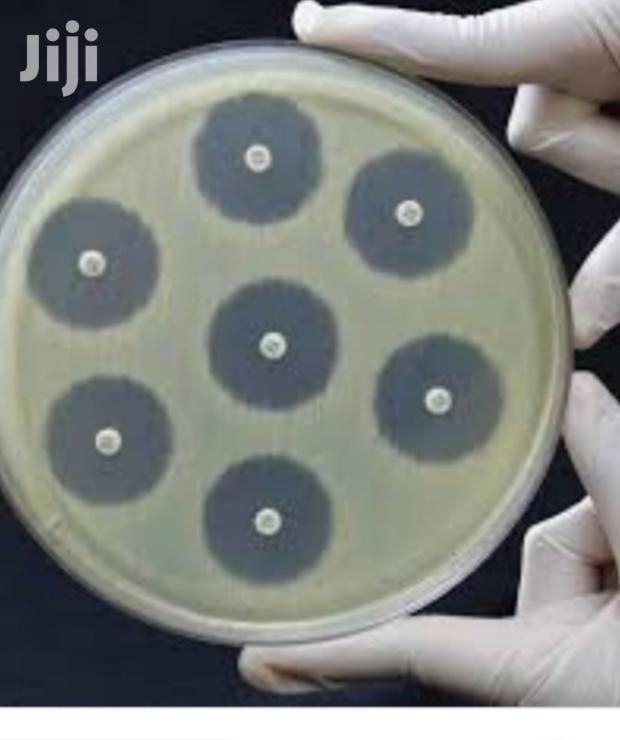
Sensitivity Discs 2/4 - main view

Sensitivity Discs 2/4

Product Description
Free delivery within cbdCountry wide delivery can be arranged
Specifications
- Condition
- Not Specified
- Availability
- In Stock
Customer Reviews
Please log in to submit a review.
Log inLoading reviews...
Please log in to submit a review.
Log in